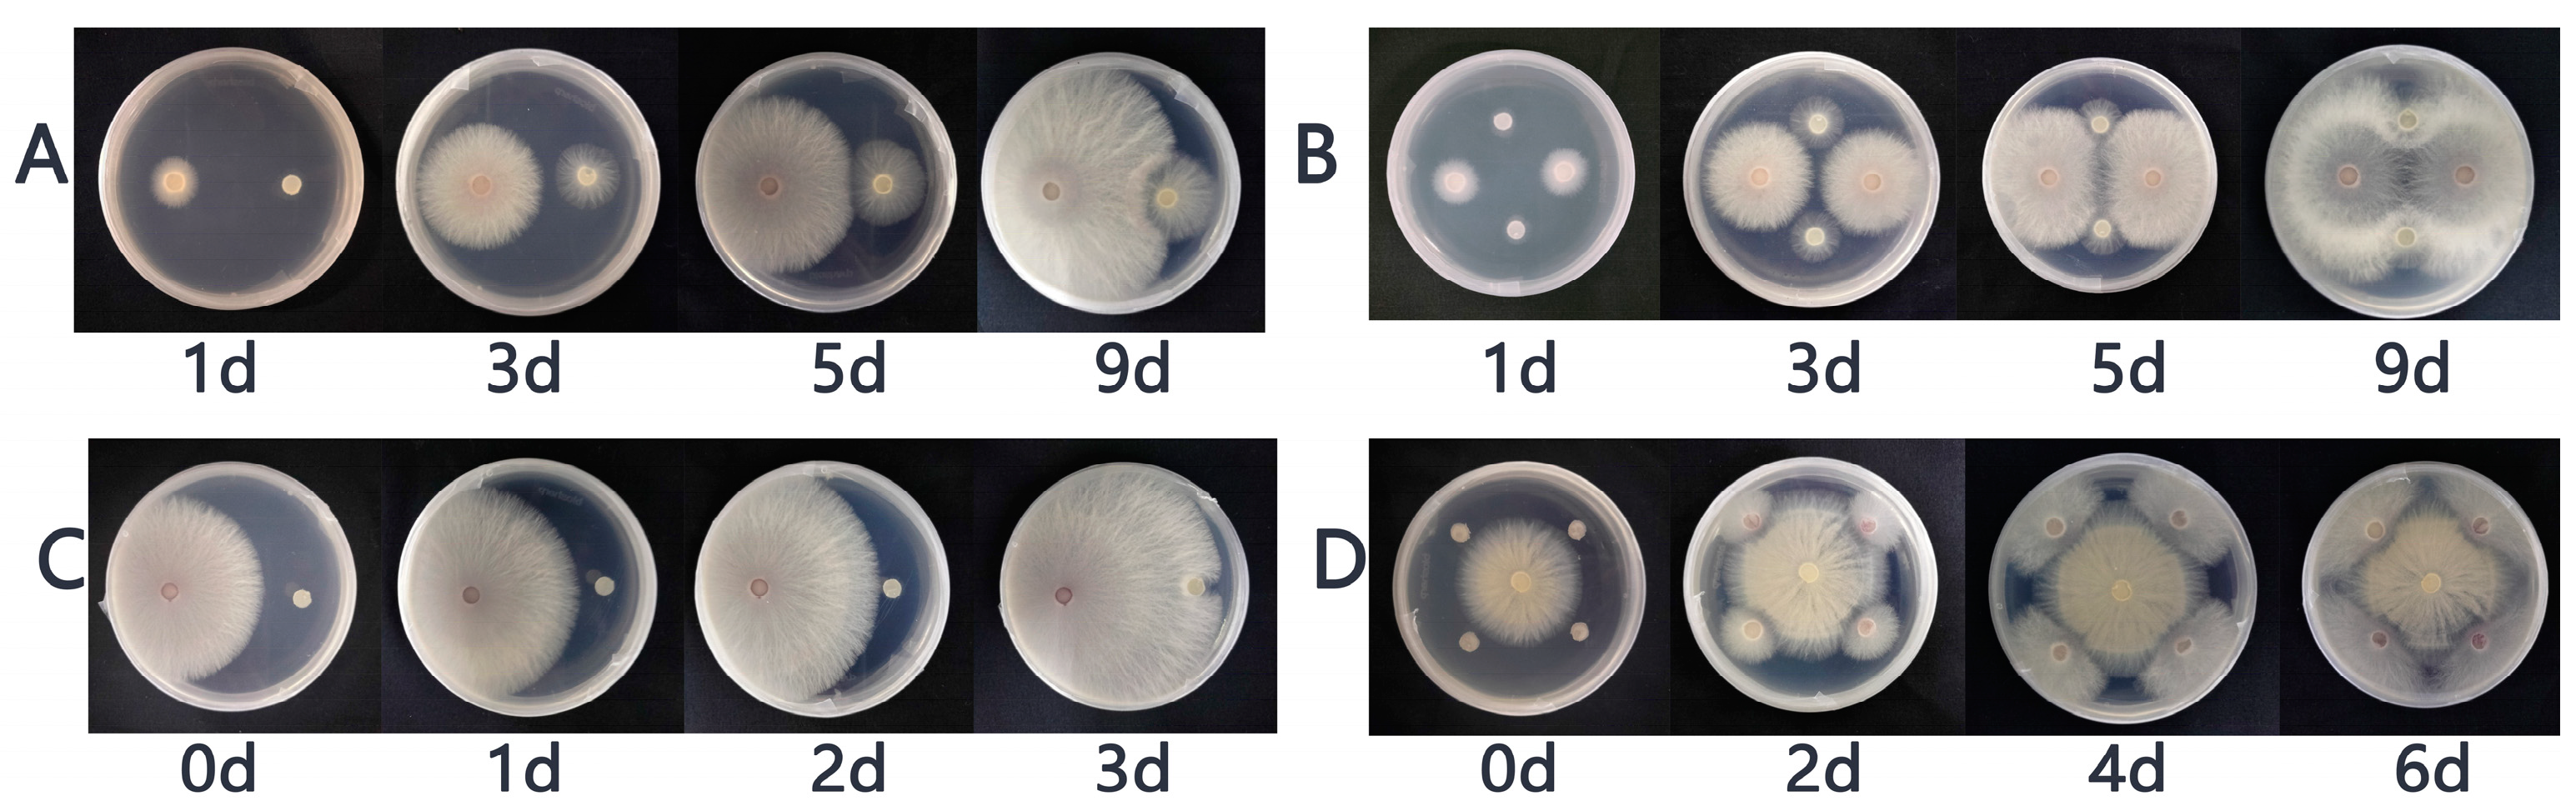
Horticulturae 10 00240 g001 Horticulturae 10 00240 g001

Piriformospora indica Enhances Resistance to Fusarium wilt in Strawberry by Increasing the Activity of Superoxide Dismutase, Peroxidase, and Catalase, While Reducing the Content of Malondialdehyde in the Roots
Abstract
1. Introduction
2. Materials and Methods
2.1. Experimental Materials
2.2. Experimental Design
2.3. Dual Culture of P. indica and Fof
2.4. Calculation of Disease Index
2.5. Determination of Strawberry Growth, and Physiological and Biochemical Indexes
2.6. Statistical Analysis
3. Results
3.1. The Results of the Plate Confrontation between P. indica and Fof
3.2. Detection of P. indica Colonization in the Roots of Strawberry Plantlets
3.3. Calculation DI
3.4. Effects of P. indica on Strawberry Phenotypes under Fof Stress
3.5. Effects of P. indica on Strawberry Growth under Fof Stress
3.6. Effects of P. indica on the Antioxidant Oxidase Activity of Strawberry under Fof Stress
3.7. Effects of P. indica on the MDA Content of Strawberry under Fof Stress
4. Discussion
5. Conclusions
Author Contributions
Funding
Data Availability Statement
Acknowledgments
Conflicts of Interest
References
- Xu, C.; Zhang, X.; Liang, J.; Fu, Y.; Wang, J.; Jiang, M.; Pan, L. Cell wall and reactive oxygen metabolism responses of strawberry fruit during storage to low voltage electrostatic field treatment. Postharvest Biol. Technol. 2022, 192, 112017. [Google Scholar] [CrossRef]
- Zhang, Y.; Lei, J.; Zhao, M.; Zhang, Y.; Wang, G.; Zhong, C.; Chang, L.; Ning, Z.; Sun, R.; Wang, B.; et al. Fruit scientific research in new China in the past 70 years: Strawberry. J. Fruit Sci. 2019, 36, 1441–1452. [Google Scholar]
- Dilla-Ermita, C.J.; Goldman, P.H.; Jaime, J.H.; Ramos, G.; Pennerman, K.K.; Henry, P.M. First report of Fusarium oxysporum f. sp. fragariae race 2 causing fusarium wilt of strawberry (Fragaria × ananassa) in California. Plant Dis. 2023, 107, 2579–2897. [Google Scholar] [CrossRef] [PubMed]
- Koike, S.T.; Gordon, T.R. Management of fusarium wilt of strawberry. Crop Prot. 2015, 73, 67–72. [Google Scholar] [CrossRef]
- Nam, M.; Kang, Y.; Lee, I.; Kim, H.; Chun, C. Infection of daughter plants by Fusarium oxysporum f. sp. fragariae through runner propagation of strawberry. Hortic. Sci. Technol. 2011, 29, 273–277. [Google Scholar]
- Wang, Y.; Zhao, X.; Yin, B.; Zhen, W.; Guo, J. BiochemicaL defenses induced by mycorrhizae fungi glomus mosseae in controlling strawberry fusarium wilt. Open Biomed. Eng. J. 2015, 9, 301–304. [Google Scholar] [CrossRef]
- Subbarao, K.V.; Kabir, Z.; Martin, F.N.; Koike, S.T. Management of soilborne diseases in strawberry using vegetable rotations. Plant Dis. 2007, 91, 964–972. [Google Scholar] [CrossRef] [PubMed]
- Njoroge, S.M.C.; Kabir, Z.; Martin, F.N.; Koike, S.T.; Subbarao, K.V. Comparison of crop rotation for verticillium wilt management and effect on pythium species in conventional and organic strawberry production. Plant Dis. 2009, 93, 519–527. [Google Scholar] [CrossRef]
- Hernández-Muñiz, P.; Borrero, C.; Ordóñez-Martín, J.; Pastrana, A.M.; Avilés, M. Optimization of the use of industrial wastes in anaerobic soil disinfestation for the control of fusarium wilt in strawberry. Plants 2023, 12, 3185. [Google Scholar] [CrossRef]
- Chen, Y.; Xu, Y.; Zhou, T.; Akkaya, M.S.; Wang, L.; Li, S.; Li, X. Biocontrol of fusarium wilt disease in strawberries using bioorganic fertilizer fortified with Bacillus licheniformis X-1 and Bacillus methylotrophicus Z-1. 3 Biotech 2020, 10, 80. [Google Scholar] [CrossRef]
- Li, D.; Bodjrenou, D.M.; Zhang, S.; Wang, B.; Pan, H.; Yeh, K.-W.; Lai, Z.; Cheng, C. The endophytic fungus Piriformospora indica reprograms banana to cold resistance. Int. J. Mol. Sci. 2021, 22, 4973. [Google Scholar] [CrossRef] [PubMed]
- Waller, F.; Achatz, B.; Baltruschat, H.; Fodor, J.; Becker, K.; Fischer, M.; Heier, T.; Hückelhoven, R.; Neumann, C.; von Wettstein, D.; et al. The endophytic fungus Piriformospora indica reprograms barley to salt-stress tolerance, disease resistance, and higher yield. Proc. Natl. Acad. Sci. USA 2005, 102, 13386–13391. [Google Scholar] [CrossRef] [PubMed]
- Rai, M.; Varma, A. Arbuscular mycorrhiza-like biotechnological potential of Piriformospora indica, which promotes the growth of Adhatoda vasica Nees. Electron. J. Biotechnol. 2005, 8, 107–112. [Google Scholar] [CrossRef]
- Mensah, R.A.; Li, D.; Liu, F.; Tian, N.; Sun, X.; Hao, X.; Lai, Z.; Cheng, C. Versatile Piriformospora indica and its potential applications in horticultural crops. Hortic. Plant J. 2020, 6, 111–121. [Google Scholar] [CrossRef]
- Li, L.; Hao, R.; Yang, X.; Feng, Y.; Bi, Z. Piriformospora indica increases resistance to Fusarium pseudograminearum in wheat by inducing phenylpropanoid pathway. Int. J. Mol. Sci. 2023, 24, 8797. [Google Scholar] [CrossRef]
- Li, L.; Guo, N.; Feng, Y.; Duan, M.; Li, C. Effect of Piriformospora indica-induced systemic resistance and basal immunity against Rhizoctonia cerealis and Fusarium graminearum in wheat. Front. Plant Sci. 2022, 13, 836940. [Google Scholar] [CrossRef] [PubMed]
- Rabiey, M.; Shaw, M.W. Piriformospora indica reduces fusarium head blight disease severity and mycotoxin DON contamination in wheat under UK weather conditions. Plant Pathol. 2016, 65, 940–952. [Google Scholar] [CrossRef]
- Rabiey, M.; Ullah, I.; Shaw, M.W. The endophytic fungus Piriformospora indica protects wheat from fusarium crown rot disease in simulated UK autumn conditions. Plant Pathol. 2015, 64, 1029–1040. [Google Scholar] [CrossRef]
- Harrach, B.D.; Baltruschat, H.; Barna, B.; Fodor, J.; Kogel, K.-H. The mutualistic fungus Piriformospora indica protects barley roots from a loss of antioxidant capacity caused by the necrotrophic pathogen Fusarium culmorum. Mol. Plant-Microbe Interact. 2013, 26, 599–605. [Google Scholar] [CrossRef]
- Wu, H.; Wang, B.; Hao, X.; Zhang, Y.; Wang, T.; Lu, Z.; Lai, Z.; Cheng, C. Piriformospora indica promotes the growth and enhances the root rot disease resistance of gerbera. Sci. Hortic. 2022, 297, 110946. [Google Scholar] [CrossRef]
- Sinijadas, K.; Amitha, P.; Radhika, N.S.; Manju, R.V.; Joy Michal, J. Beneficial fungal root endophyte Piriformospora indica diminishes yield loss without compromising quality of banana fruits due to banana bract mosaic virus infection through better soil nutrient mobilization. Int. J. Plant Soil Sci. 2023, 35, 1397–1415. [Google Scholar] [CrossRef]
- Safeer, M.M.; Susha, S.T. Integrated management of Cymbidium mosaic disease in commercial Dendrobium orchids using root endophytic fungi Piriformospora indica. Cogent Food Agric. 2022, 8, 2139848. [Google Scholar] [CrossRef]
- Fakhro, A.; Andrade-Linares, D.R.; von Bargen, S.; Bandte, M.; Buettner, C.; Grosch, R.; Schwarz, D.; Franken, P. Impact of Piriformospora indica on tomato growth and on interaction with fungal and viral pathogens. Mycorrhiza 2010, 20, 191–200. [Google Scholar] [CrossRef]
- Cheng, C.; Li, D.; Qi, Q.; Sun, X.; Anue, M.R.; David, B.M.; Zhang, Y.; Hao, X.; Zhang, Z.; Lai, Z. The root endophytic fungus Serendipita indica improves resistance of banana to Fusarium oxysporum f. sp. cubense tropical race 4. Eur. J. Plant Pathol. 2020, 156, 87–100. [Google Scholar] [CrossRef]
- Song, X.; Mei, F.z.; LI, X.; Zhu, Y.; Shi, F.; Liu, J. Screening and control effect of antagonistic bacteria against strawberry fusarium wilt. Chin. J. Biol. Control 2022, 38, 653–661. [Google Scholar]
- Varma, A.; Verma, S.; Sudha; Sahay, N.; Bütehorn, B.; Franken, P. Piriformospora indica, a cultivable plant-growth-promoting root endophyte. Appl. Environ. Microbiol. 1999, 65, 2741–2744. [Google Scholar] [CrossRef]
- Cao, Z.; Fan, T.; Bi, Y.; Tian, G.; Zhang, L. Potassium deficiency and root exudates reduce root growth and increase Fusarium oxysporum growth and disease incidence in continuously cultivated strawberry. N. Z. J. Crop Hortic. Sci. 2016, 44, 58–68. [Google Scholar] [CrossRef]
- Zhang, X.; Zhou, Z.; Li, X.; Li, H. The effect of potassium treatment on the growth and fruit quality of ‘Yanli’ strawberry. China Fruits 2022, 222, 29–33. [Google Scholar]
- Trzewik, A.; Maciorowski, R.; Klocke, E.; Orlikowska, T. The influence of Piriformospora indica on the resistance of two rhododendron cultivars to Phytophthora cinnamomi and P. plurivora. Biol. Control 2020, 140, 104121. [Google Scholar] [CrossRef]
- Cheng, C.; Li, D.; Wang, B.; Liao, B.; Qu, P.; Liu, W.; Zhang, Y.; Lü, P. Piriformospora indica colonization promotes the root growth of Dimocarpus longan seedlings. Sci. Hortic. 2022, 301, 111137. [Google Scholar] [CrossRef]
- Ghanem, G.; Ewald, A.; Zerche, S.; Hennig, F. Effect of root colonization with Piriformospora indica and phosphate availability on the growth and reproductive biology of a Cyclamen persicum cultivar. Sci. Hortic. 2014, 172, 233–241. [Google Scholar] [CrossRef]
- Lin, H.; Xiong, J.; Zhou, H.; Chen, C.; Lin, F.; Xu, X.; Oelmueller, R.; Xu, W.; Yeh, K. Growth promotion and disease resistance induced in Anthurium colonized by the beneficial root endophyte Piriformospora indica. BMC Plant Biol. 2019, 19, 40. [Google Scholar] [CrossRef]
- Taghinasab, M.; Imani, J.; Steffens, D.; Glaeser, S.P.; Kogel, K.-H. The root endophytes Trametes versicolor and Piriformospora indica increase grain yield and P content in wheat. Plant Soil 2018, 426, 339–348. [Google Scholar] [CrossRef]
- Kumar, V.; Sarma, M.V.R.K.; Saharan, K.; Srivastava, R.; Kumar, L.; Sahai, V.; Bisaria, V.S.; Sharma, A.K. Effect of formulated root endophytic fungus Piriformospora indica and plant growth promoting rhizobacteria fluorescent pseudomonads R62 and R81 on Vigna mungo. World J. Microbiol. Biotechnol. 2012, 28, 595–603. [Google Scholar] [CrossRef] [PubMed]
- Sherameti, I.; Shahollari, B.; Venus, Y.; Altschmied, L.; Varma, A.; Oelmüller, R. The endophytic fungus Piriformospora indica stimulates the expression of nitrate reductase and the starch-degrading enzyme glucan-water dikinase in tobacco and Arabidopsis roots through a homeodomain transcription factor that binds to a conserved motif in their promoters. J. Biol. Chem. 2005, 280, 26241–26247. [Google Scholar] [CrossRef]
- Liu, W.; Tan, M.; Qu, P.; Huo, C.; Liang, W.; Li, R.; Jia, Y.; Fan, X.; Cheng, C. Use of Piriformospora indica to promote growth of strawberry daughter plants. Horticulturae 2022, 8, 370. [Google Scholar] [CrossRef]
- Parida, A.K.; Das, A.B.; Mohanty, P. Defense potentials to NaCl in a mangrove, Bruguiera parviflora: Differential changes of isoforms of some antioxidative enzymes. J. Plant Physiol. 2004, 161, 531–542. [Google Scholar] [CrossRef] [PubMed]
- Khaleghi, A.; Naderi, R.; Brunetti, C.; Maserti, B.E.; Salami, S.A.; Babalar, M. Morphological, physiochemical and antioxidant responses of Maclura pomifera to drought stress. Sci. Rep. 2019, 9, 19250. [Google Scholar] [CrossRef]
- Roylawar, P.; Khandagale, K.; Randive, P.; Shinde, B.; Murumkar, C.; Ade, A.; Singh, M.; Gawande, S.; Morelli, M. Piriformospora indica primes onion response against stemphylium leaf blight disease. Pathogens 2021, 10, 1085. [Google Scholar] [CrossRef] [PubMed]
- Kumar, M.; Yadav, V.; Tuteja, N.; Johri, A.K. Antioxidant enzyme activities in maize plants colonized with Piriformospora indica. Microbiology 2009, 155, 780–790. [Google Scholar] [CrossRef] [PubMed]
- Narayan, O.P.; Verma, N.; Singh, A.K.; Oelmüller, R.; Kumar, M.; Prasad, D.; Kapoor, R.; Dua, M.; Johri, A.K. Antioxidant enzymes in chickpea colonized by Piriformospora indica participate in defense against the pathogen Botrytis cinerea. Sci. Rep. 2017, 7, 13553. [Google Scholar] [CrossRef] [PubMed]
- Nassimi, Z.; Taheri, P. Endophytic fungus Piriformospora indica induced systemic resistance against rice sheath blight via affecting hydrogen peroxide and antioxidants. Biocontrol Sci. Technol. 2017, 27, 252–267. [Google Scholar] [CrossRef]
- Sun, C.; Johnson, J.; Cai, D.; Sherameti, I.; Oelmueller, R.; Lou, B. Piriformospora indica confers drought tolerance in Chinese cabbage leaves by stimulating antioxidant enzymes, the expression of drought-related genes and the plastid-localized CAS protein. J. Plant Physiol. 2010, 167, 1009–1017. [Google Scholar] [CrossRef]
- Dan, L.; Mensah, R.A.; Fan, L.; Na, T.; Quan, Q.; Yeha, K.; Xu, X.; Chen, C.; Lai, Z. Effects of Piriformospora indica on rooting and growth of tissue-cultured banana (Musa acuminata cv. Tianbaojiao) seedlings. Sci. Hortic. 2019, 257, 108649. [Google Scholar] [CrossRef]
- Yaghoubian, Y.; Goltapeh, E.M.; Pirdashti, H.; Esfandiari, E.; Feiziasl, V.; Dolatabadi, H.K.; Varma, A.; Hassim, M.H. Effect of Glomus mosseae and Piriformospora indica on growth and antioxidant defense responses of wheat plants under drought stress. Agric. Res. 2014, 3, 239–245. [Google Scholar] [CrossRef]
- Hao, R.; Li, L.; Yang, X.; Ma, H.; Shi, S.; Feng, Y. Endophytic fungus Piriformospora indica induces wheats against root rot. Acta Microbiol. Sin. 2023, 63, 3292–3309. [Google Scholar] [CrossRef]
- Rodríguez-Yzquierdo, G.; Olivares, B.O.; González-Ulloa, A.; León-Pacheco, R.; Gómez-Correa, J.C.; Yacomelo-Hernández, M.; Carrascal-Pérez, F.; Florez-Cordero, E.; Soto-Suárez, M.; Dita, M.; et al. Soil predisposing factors to Fusarium oxysporum f.sp Cubense tropical race 4 on banana crops of La Guajira, Colombia. Agronomy 2023, 13, 2588. [Google Scholar] [CrossRef]
- Rodríguez-Yzquierdo, G.; Olivares, B.O.; Silva-Escobar, O.; González-Ulloa, A.; Soto-Suarez, M.; Betancourt-Vásquez, M. Mapping of the susceptibility of colombian musaceae lands to a deadly disease: Fusarium oxysporum f. sp. cubense tropical race 4. Horticulturae 2023, 9, 757. [Google Scholar] [CrossRef]
- Mejías Herrera, R.; Hernández, Y.; Magdama, F.; Mostert, D.; Bothma, S.; Paredes Salgado, E.M.; Terán, D.; González, E.; Angulo, R.; Angel, L.; et al. First Report of fusarium wilt of cavendish bananas caused by Fusarium oxysporum f. sp. cubense tropical race 4 in Venezuela. Plant Dis. 2023, 107, 3297. [Google Scholar] [CrossRef]
- Olivares Campos, B.O. Evaluation of the incidence of banana wilt and its relationship with soil properties. In Banana Production in Venezuela: Novel Solutions to Productivity and Plant Health; Olivares Campos, B.O., Ed.; Springer Nature: Cham, Switzerland, 2023; pp. 95–117. [Google Scholar] [CrossRef]

| Treatment | Disease Rate | DI | Efficiency |
|---|---|---|---|
| F | 100% | 63 | - |
| PF | 80% | 46 | 27% |
Disclaimer/Publisher’s Note: The statements, opinions and data contained in all publications are solely those of the individual author(s) and contributor(s) and not of MDPI and/or the editor(s). MDPI and/or the editor(s) disclaim responsibility for any injury to people or property resulting from any ideas, methods, instructions or products referred to in the content. |
© 2024 by the authors. Licensee MDPI, Basel, Switzerland. This article is an open access article distributed under the terms and conditions of the Creative Commons Attribution (CC BY) license (https://creativecommons.org/licenses/by/4.0/).
Share and Cite
Huang, Y.; Li, J.; Nong, C.; Lin, T.; Fang, L.; Feng, X.; Chen, Y.; Lin, Y.; Lai, Z.; Miao, L. Piriformospora indica Enhances Resistance to Fusarium wilt in Strawberry by Increasing the Activity of Superoxide Dismutase, Peroxidase, and Catalase, While Reducing the Content of Malondialdehyde in the Roots. Horticulturae 2024, 10, 240. https://doi.org/10.3390/horticulturae10030240
Huang Y, Li J, Nong C, Lin T, Fang L, Feng X, Chen Y, Lin Y, Lai Z, Miao L. Piriformospora indica Enhances Resistance to Fusarium wilt in Strawberry by Increasing the Activity of Superoxide Dismutase, Peroxidase, and Catalase, While Reducing the Content of Malondialdehyde in the Roots. Horticulturae. 2024; 10(3):240. https://doi.org/10.3390/horticulturae10030240
Chicago/Turabian StyleHuang, Yuji, Jinman Li, Chaocui Nong, Tong Lin, Li Fang, Xu Feng, Yiting Chen, Yuling Lin, Zhongxiong Lai, and Lixiang Miao. 2024. "Piriformospora indica Enhances Resistance to Fusarium wilt in Strawberry by Increasing the Activity of Superoxide Dismutase, Peroxidase, and Catalase, While Reducing the Content of Malondialdehyde in the Roots" Horticulturae 10, no. 3: 240. https://doi.org/10.3390/horticulturae10030240
APA StyleHuang, Y., Li, J., Nong, C., Lin, T., Fang, L., Feng, X., Chen, Y., Lin, Y., Lai, Z., & Miao, L. (2024). Piriformospora indica Enhances Resistance to Fusarium wilt in Strawberry by Increasing the Activity of Superoxide Dismutase, Peroxidase, and Catalase, While Reducing the Content of Malondialdehyde in the Roots. Horticulturae, 10(3), 240. https://doi.org/10.3390/horticulturae10030240

